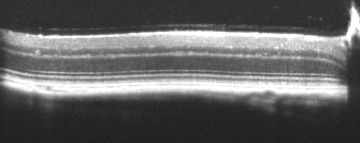
Bioptigen sdOCT Retinal Image

Live Imaging and Functional Evaluation (LIFE) Core
The LIFE Core component offers a broad range of in vivo functional and structural testing that can be customized to the needs of the investigator’s specific research interests, focus and hypotheses. Our investigators have used the LIFE Core to define the structural and functional phenotypes in acquired or newly generated mouse mutants to confirm whether they display the expected phenotypes, visual behavior and/or electrophysiological responses. In addition, investigators have used the LIFE Core to document the natural history of disease in mouse models of ocular disease before they are used for interventional experiments, including those that are viral vector, stem cell, or pharmacologically based.
To use instrumentation provided in the LIFE Core, please contact the core Director (Dr Nusinowitz) or the lead module technician ([email protected]). The module directors review each application and, when appropriate, meet with the investigator to discuss the specific research needs. The lead technician will be available to assist investigators with designing and running experiments and the training and use of component instruments.
Functional evaluation
Celeris (ERG, pERG, mfERG
Electroretinography (ERG) is used to evaluate the functional status of rod- and cone- mediated retinal signaling pathways, either panretinally (full-field ERG) or in local retinal areas (multi-focal ERG; pattern ERG).

I-Systems (ERG, VCEP
The Visually-Evoked Cortical Response (VECP) is used to evaluate visual pathway function and visual acuity/contrast sensitivity at the level of the visual cortex.

Pupillometry System
A custom pupillometry system evaluates the ocular response to light of various intensities and chromaticity.
Structural Evaluation
Micron Fundus Imaging System
The Micron Fundus Imaging system provides live-imaging of the fundus, retinal autofluorescence and fluorescein/indocyanine angiography.

Bioptigen sdOCT Imaging System
The Visually-Evoked Cortical Response (VECP) is used to evaluate visual pathway function and visual acuity/contrast sensitivity at the level of the visual cortex.

Sample Bioptigen sdOCT Imagery:
Retina
Anterior Segment

Subretinal Injection

Ciliary Body
